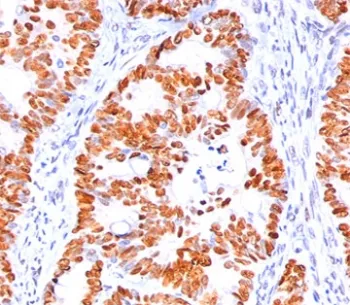
p53 Antibody / TP53 (N-Terminal Region) - image 1

p53 Antibody / TP53 (N-Terminal Region)
CAT:
800-V2282SAF-100UG
Size:
100 µg
Price:
Ask
- Availability: 24/48H Stock Items & 2 to 6 Weeks non Stock Items.
- Dry Ice Shipment: No

p53 Antibody / TP53 (N-Terminal Region)
Description:
This antibody is specific for a 53kDa protein, which is identified as p53 suppressor gene product. It reacts with the mutant as well as the wild form of p53 under denaturing and non-denaturing conditions. The antibody epitope maps within the N-terminus (aa 20-25) of p53 oncoprotein. p53 is a tumor suppressor gene expressed in a wide variety of tissue types and is involved in regulating cell growth, replication, and apoptosis. It binds to MDM2, SV40 T antigen and human papilloma virus E6 protein. Positive nuclear staining with p53 antibody has been reported to be a negative prognostic factor in breast carcinoma, lung carcinoma, colorectal, and urothelial carcinoma. antibody to p53 positivity has also been used to differentiate uterine serous carcinoma from endometrioid carcinoma as well as to detect intratubular germ cell neoplasia. Mutations involving p53 are found in a wide variety of malignant tumors, including breast, ovarian, bladder, colon, lung, and melanoma.Host:
MouseImmunogen:
Recombinant human wild-type p53 protein was used as the immunogen for this antibody.Clonality:
MonoclonalIsotype:
IgG2a κApplications:
WB, IHC-PFormat:
PurifiedBuffer:
1 mg/ml in 1X PBS; BSA free, sodium azide freeReconstitution:
Store the p53 antibody at 2-8oC (with azide) or aliquot and store at -20oC or colder (without azide).Limitations:
This p53 antibody is available for research use only.CAS Number:
9007-83-4